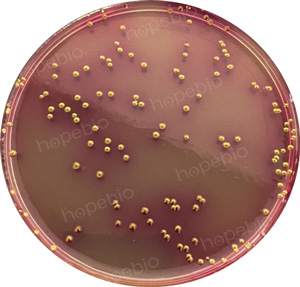

海博微信公众号
海博天猫旗舰店




引言
河水作为自然开放水体,其成分复杂多变,受周边环境、气候条件、人类活动等多重因素影响,成为多种细菌的天然栖息地。这些细菌中,部分为无害的腐生菌,而有些则是致病性细菌,一旦通过皮肤接触、黏膜感染或误食河水侵入人体,可能引发一系列疾病,从轻微的皮肤炎症、消化道不适,到严重的败血症、脑膜炎等,对人体健康造成不同程度的损害。
一、河水中细菌的来源与分布规律
河水中细菌来源分自然与人为两类,其分布受多重因素影响,呈现明显规律。
1、细菌的主要来源
自然来源中,土壤细菌经地表径流冲入河流,底泥细菌在水流扰动下悬浮于水体,水生生物代谢及死亡分解也会释放细菌。
人为来源是致病菌增多的主因:生活污水携带大量肠道细菌;农田有机肥、畜禽粪便随雨水入河,带入致病菌和寄生虫卵;工业废水、垃圾倾倒及水上活动,进一步增加致病菌污染风险。
2、分布规律
空间上,上游细菌总量低、以腐生菌为主,中游受城镇、农田污染,致病菌比例上升,下游底泥细菌积累多;岸边、浅水区等水流平缓处细菌浓度高于深水区。
时间上,夏季高温多雨,细菌繁殖快且地表径流带入更多污染物,细菌数量激增;暴雨后1-3天细菌浓度达峰值,游泳风险极高,冬季细菌总量则显著减少。
二、河水中常见致病性细菌及危害详解
致病性细菌按致病部位可分为肠道致病菌、皮肤黏膜致病菌、呼吸道及全身感染致病菌三类,以下详解其核心危害。
1、肠道致病菌:误食河水后的主要威胁
肠道致病菌通过粪便污染河水,人体误食污染河水或接触后未洗手进食,会引发消化道症状。
(1)大肠菌群
大肠菌群是指那些能在37℃48 h之内发酵乳糖产酸产气的、需氧及兼性厌氧的革兰氏阴性的无芽孢杆菌。主要包括有埃希氏菌属、柠檬酸杆菌属、肠杆菌属、克雷伯氏菌属等菌属的细菌。
根据致病性的不同,致泻性大肠埃希菌被分为产肠毒素性大肠埃希菌、肠道侵袭性大肠埃希菌、肠道致病性大肠埃希菌、肠集聚性黏附性大肠埃希菌和肠出血性大肠埃希菌其中肠出血性大肠杆菌(如O157:H7菌株)危害最甚,可产生志贺样毒素,引发严重并发症。感染途径以粪-口为主,潜伏期3-4天,典型症状为突发腹痛、水样腹泻,部分患者出现血便,老人、儿童等易感人群可能引发溶血性尿毒综合征,危及生命。
暴雨后受污染河流的浅水区风险极高,岸边受污染的沙土、石块也可能间接传播病菌。
图1 大肠菌群在品红亚硫酸钠培养基上的特征
沙门氏菌为革兰氏阴性杆菌,致病血清型主要有伤寒、副伤寒、鼠伤寒沙门氏菌等,存在于畜禽肠道,经粪便污染河水,是引发肠道感染的重要致病菌。
该菌侵入肠道后繁殖产毒,破坏黏膜屏障并引发全身症状,主要通过粪-口途径传播,误食污染河水是重要感染方式。潜伏期6 h-72 h,症状为发热、腹痛、水样腹泻,重症者可能引发败血症、脑膜炎;伤寒及副伤寒沙门氏菌感染症状更重,病程长且恢复期久。
畜禽养殖场、农田附近河流风险较高,夏季高温会加剧感染风险。

图2 沙门氏菌在酚红煌绿平板和亚硫酸铋平板上的生长特征
副溶血性弧菌为革兰氏阴性嗜盐弧菌,多见于河口咸淡水区域,夏季高温易繁殖,可通过粪便污染或海洋生物携带进入河水。
该菌产生多种毒素损伤肠道黏膜,经粪-口途径传播,误食污染河水或河鲜均可能感染。潜伏期1-24小时,症状为腹痛、腹泻、呕吐,重症者可脱水、休克,多数患者1-7天可自愈。
河口、海水倒灌区域及夏季浅水区风险高,生食河鲜或接触后未洗手进食也易感染。
图3 弧菌在TCBS琼脂平板上的生长特征
此类细菌可通过破损皮肤或黏膜接触侵入人体,引发皮肤、眼、耳等部位炎症。
铜绿假单胞菌为革兰氏阴性需氧菌,广泛存在于自然环境,属条件致病菌,耐药性强,存活能力突出。
其产生多种毒素和酶破坏组织细胞,主要通过破损皮肤或黏膜接触感染。
皮肤感染可出现红斑、水疱、溃疡,眼部感染引发结膜炎、角膜炎甚至失明,外耳道感染导致红肿流脓,免疫力低下者还可能引发肺炎、尿路感染。
夏季浅水区及未清洁的泳具易滋生该菌,感染风险较高。
链球菌为革兰氏阳性球菌,乙型溶血性链球菌致病性最强,存在于人和动物体内,可通过飞沫、粪便污染河水。
其产生的毒素和酶可破坏血细胞、促进细菌扩散,破损皮肤接触污染河水是主要感染途径。
皮肤感染可引发蜂窝织炎、丹毒,重症者细菌侵入血液导致败血症,还可能引发呼吸道疾病及肾小球肾炎、风湿热等并发症。
夏季人群密集河段易传播,游泳后未及时清洁皮肤会增加感染风险。
葡萄球菌为革兰氏阳性球菌,金黄色葡萄球菌致病性最强,来自人体分泌物及粪便污染,是皮肤感染和食物中毒的常见致病菌。
其产生的毒素和酶可引发感染扩散,破损皮肤接触污染河水或污染物后触摸伤口均可能致病。
皮肤感染表现为毛囊炎、疖、痈,重症可致败血症,误食含毒素的河水或食物还会引发食物中毒。
人群密集河段及受污染的岸边沙土、石块风险较高。
三、河水游泳细菌感染的预防与应急处理
通过科学预防可降低感染风险,不慎感染后及时处理能避免病情加重,具体建议如下。
选择安全的游泳区域,优先选择上游清澈、水流湍急、无污染源的河段,避开城镇、污水厂下游、养殖场附近及浅水区、垃圾堆积处;暴雨后1-3天及河口咸淡水区域禁止游泳。
做好个人防护准备,皮肤有破损时避免游泳,佩戴泳镜、耳塞等防护用品,穿好泳衣泳裤;游泳前不宜空腹或过饱,规避溺水及误食风险。
规范游泳行为,避免戏水打闹以防呛水,每次游泳控制在1小时内;不捕捞生食河鲜,接触河鲜后务必用肥皂水洗手。
游泳后及时清洁消毒,立即用清水冲洗全身,肥皂水清洁手脸,更换衣物;泳具洗净晾干,必要时消毒;误食河水后可适量饮用温水。
特殊人群谨慎游泳,老人、儿童、孕妇、免疫力低下者及皮肤敏感者,应避免河水中游泳,优先选择室内泳池。
皮肤黏膜接触感染的应急处理,皮肤出现不适需清水冲洗、保持干燥,涂抹炉甘石洗剂缓解瘙痒,重症者及时就医;眼睛受污染用清水冲洗5-10分钟,外耳道不适需保持干燥并就医。
消化道感染的应急处理,出现腹痛、腹泻时,停止进食并补充温水或淡盐水,脱水者立即就医;血便、高热等重症需紧急就诊,排查致病菌。
全身感染的应急处理,出现高热、寒战、呼吸困难等症状,立即拨打急救电话,告知医生游泳史,以便针对性治疗。
河水中的致病菌虽隐蔽,但认清其危害、做好防护就能有效规避。科学选择游泳区域、规范防护及清洁流程,是守护健康的关键。
保护河水环境、减少人为污染,是从源头降低风险的根本。愿大家既能享受河水清凉,也能守护自身健康。
五、相关培养基的采购
开云手机登录中心有适用于各种微生物检验的产品,客户可根据实际情况和用途进行选用。
|
产品编号 |
产品名称 |
规格 |
产品说明及用途 |
|
HB0118 |
250g |
用于饮用水和水源水中总大肠菌群的选择性分离和确证(GB标准) |
|
|
HB8396 |
250g |
用于饲料中沙门氏菌分离培养 |
|
|
HB4090-6 |
250g |
用于沙门氏菌选择性分离培养 |
|
|
HB4130 |
250g |
用于致病性弧菌的选择性分离 |
注:本文属海博生物原创,未经允许不得转载。
下一篇:没有了!
| 相关文章: |
